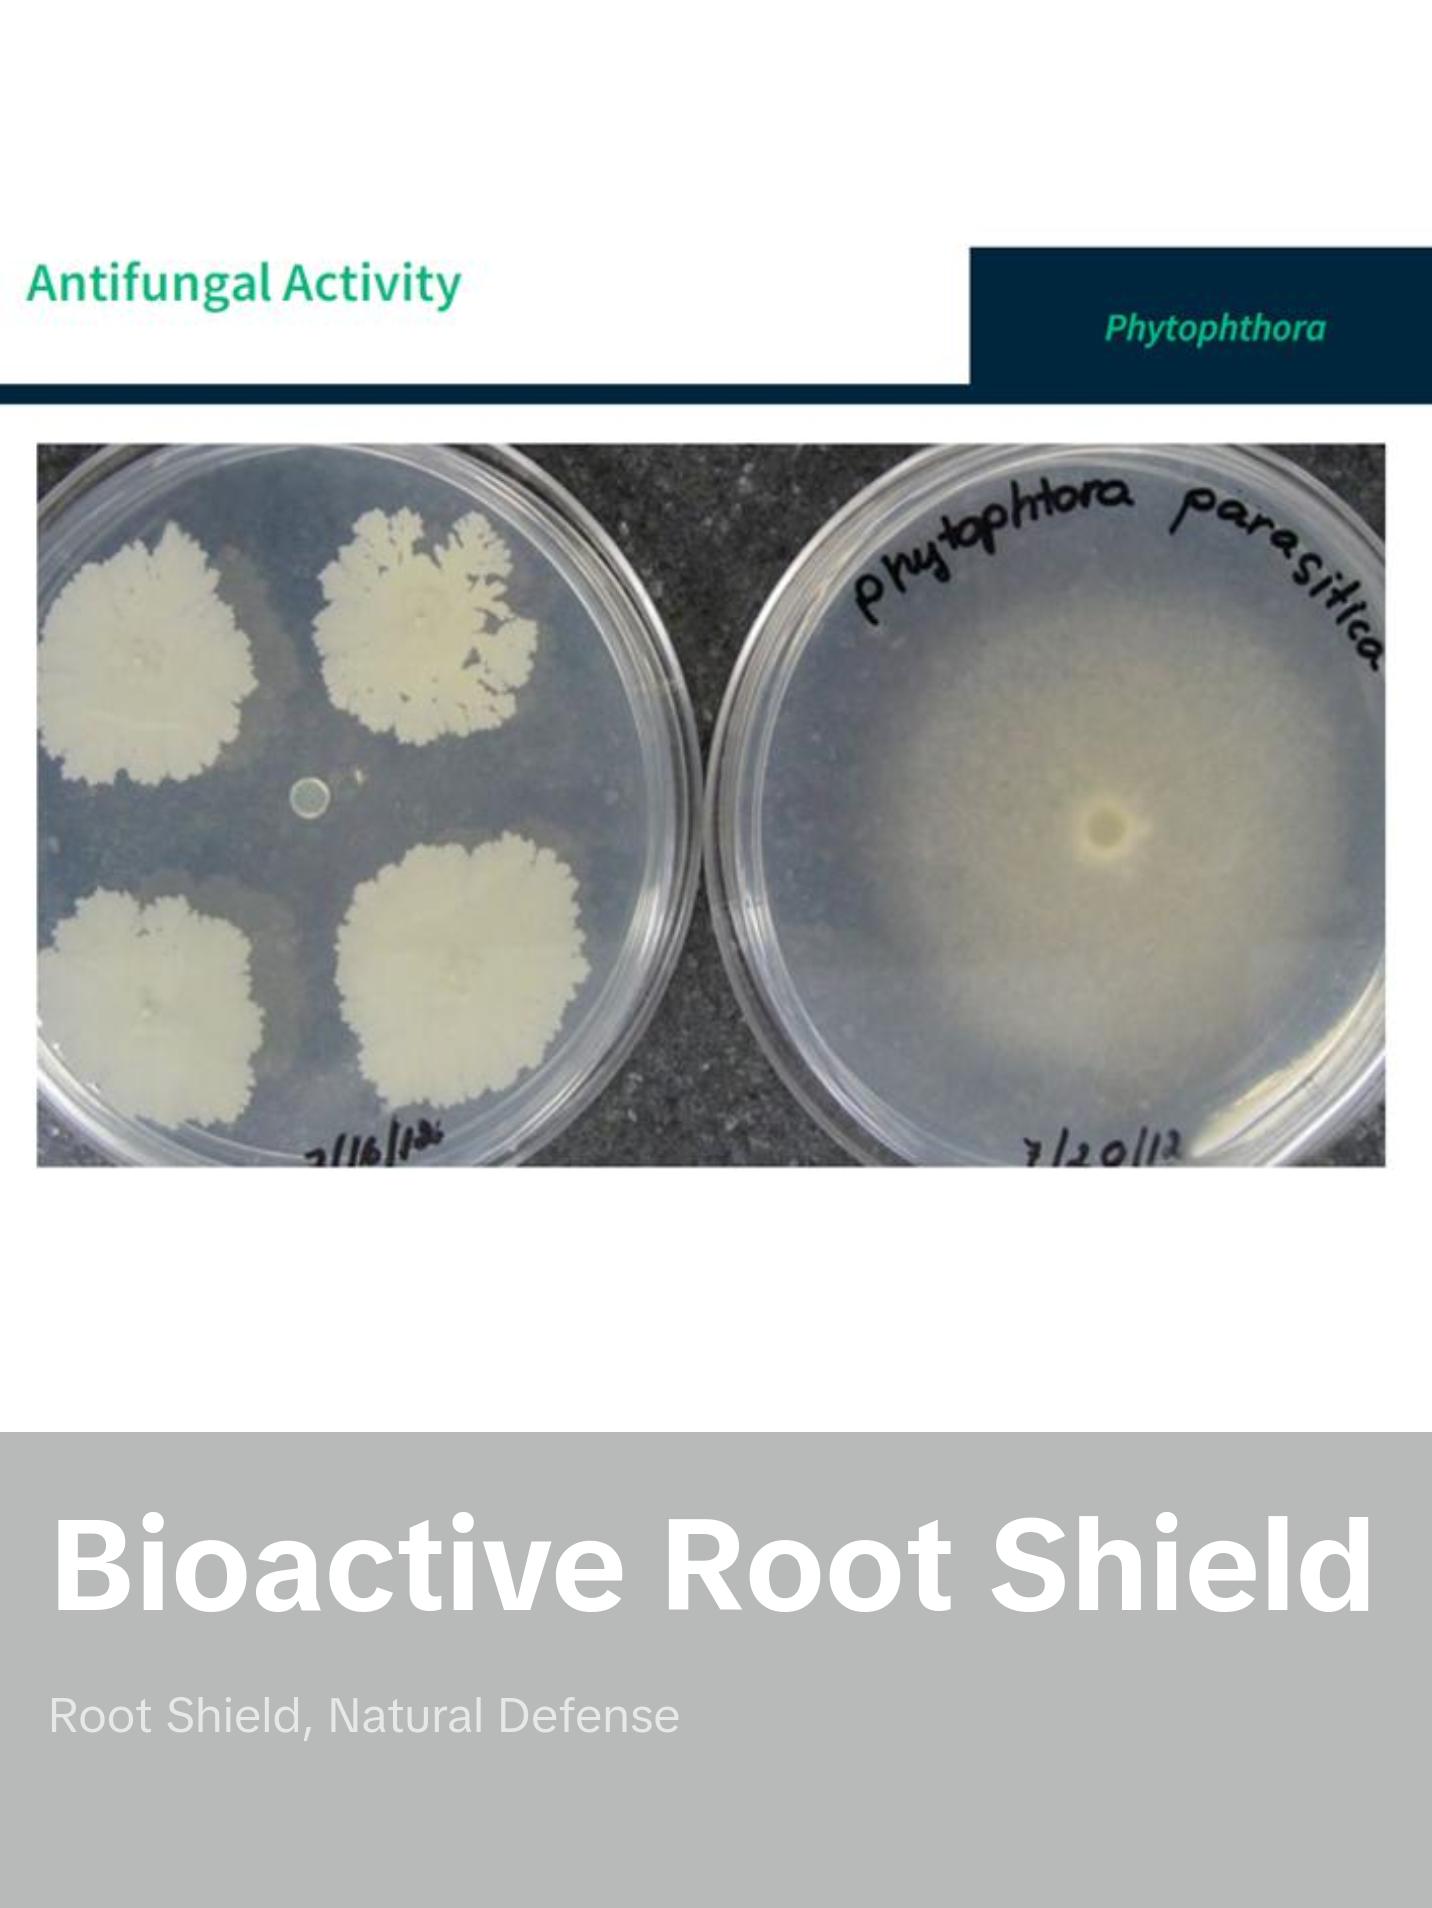
FertiPro, enzyme and bacteria for root protection, 100% Organic, BioShield Plant Protect

The recommendable concentration. (2 gr./gal. )
This product comes in a 5x5x7 box with 1 lb of biofertilizer.
FertiPro - Beneficial Microbes & Enzymes for Root Protection
Bioactive Fertilizer for Fruit Tree Production
Targeted Solution for Root Rot & Disease Prevention
FertiPro is designed specifically to combat root rot and promote robust fruit tree growth through the power of beneficial microbes and enzymes. This natural bioactive fertilizer strengthens plant immunity and minimizes the need for harmful chemicals.
Why Choose FertiPro?
✅ Effective Root Rot Prevention:
·The unique microbial blend in FertiPro stimulates systemic resistance, enhancing the plant’s natural defense mechanisms throughout the entire tree.
·Proven efficacy against Phytophthora – lab tests consistently score a perfect “3” (highest rating) in preventing fungal growth.
✅ Natural Disease & Pest Resistance:
·Beneficial bacteria form a protective barrier on plants, blocking harmful pathogens and insects from thriving.
·Reduces the need for harmful pesticides and chemicals by fortifying the plant’s immune system naturally.
✅ Eco-Friendly Solution:
·Environmentally safe, sustainable approach to fruit tree production.
·Enhances soil health while promoting stronger, healthier roots.
Application Rate:
·Mix Rate: 2 grams per gallon of water.
·Application: Mix well and apply directly to the root zone.
🌱 Try FertiPro Today - Your Eco-Friendly Partner in Fruit Tree Health!